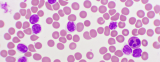
Joy Cancer Awareness Month: Expert warns parents on early signs and treatment of childhood leukaemia

Joy Cancer Awareness Month: Expert warns parents on early signs and treatment of childhood leukaemia
[Joy Online - Ghana] - 29/10/2025
A Paediatric Oncologist at the Korle-Bu Teaching Hospital, Dr Samira Yamyolia, has advised parents to pay close attention to unusual and persistent symptoms in their children, as these could signal the presence of Acute Lymphoblastic Leukaemia (ALL).
... Article published by "Joy Online" (Ghana), read more
For any information or claim on this article, see directly with the newspaper.
In Ghana newspapers
Tottenham manager Thomas Frank praises Mohammed Kudus' impact on right wing
Tottenham Hotspur manager Thomas Frank has praised Mohammed Kudus’ impact on the right wing of his team’s (…)
[Ghana Soccernet] - 21/10/2025
Maxzy lays our imperfections bare in moving new release ‘Onipa (Human)’
News Ghana, Latest Updates and Breaking News of Ghana, Osafo Daniel, https://www.newsghana.com.gh/maxzy-lays-our-imperfe
[News Ghana] - 24/10/2025
Why Climate Leadership Must Go Beyond Commitments to Implementation
Why Climate Leadership Must Go Beyond Commitments to Implementation
[Pulse] - 28/10/2025
Karim Zito blames costly errors for Kotoko’s defeat to Wydad
Asante Kotoko head coach Karim Zito says costly mistakes proved decisive in their 1-0 defeat to Morocco’s Wydad (…)
[Ghana Soccernet] - 20/10/2025
Black Queens Qualify for WAFCON 2026 After Dominant 7-0 Aggregate Win
News Ghana, Latest Updates and Breaking News of Ghana, News Ghana, https://www.newsghana.com.gh/black-queens-qualify-for
[News Ghana] - 29/10/2025




